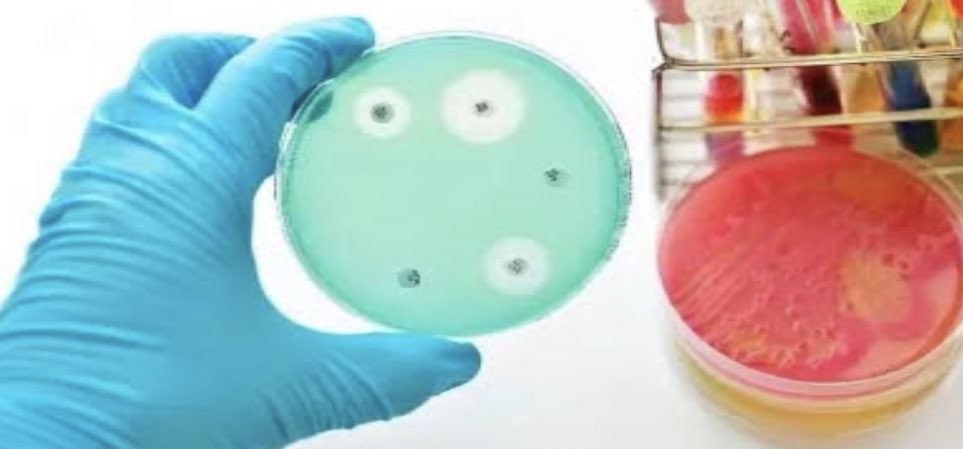

المقاومة فلا يصبح المضاد ذو تأثير على هذه الباكتيريا للعلاج بحيث تنشأ المقاومة إما بصورة طبيعية عن طريق الطفرات الجينية وإما عن طريق انتقال المقاومة من جنس اكتسبها إلى جنس آخر لم يكتسبها بعد
كما أن استعمال المضادات الحيوية لفترات طويلة يحفز ظهور الطفرات في الجينات المسببة
كما أن استعمال المضادات الحيوية لفترات طويلة يحفز ظهور الطفرات في الجينات المسببة
للمقاومة على وجه الخصوص.
🤔طيب نجي كيف تقاوم الباكتيريا المضادات الحيوية ⁉️
👩🏼🔬اولا تقوم البكتريا بتصنيع انزيمات تكسر المضادات الحيويه مثل B-lactamases هذا الانزيم يكسر المضادات الحيويه من مجموعه Penicillin
👩🏼🔬ثانيا تغير موقع فعالية المضاد مثل تغيير PBP –موقع فعاليّة البنسلين- عند
🤔طيب نجي كيف تقاوم الباكتيريا المضادات الحيوية ⁉️
👩🏼🔬اولا تقوم البكتريا بتصنيع انزيمات تكسر المضادات الحيويه مثل B-lactamases هذا الانزيم يكسر المضادات الحيويه من مجموعه Penicillin
👩🏼🔬ثانيا تغير موقع فعالية المضاد مثل تغيير PBP –موقع فعاليّة البنسلين- عند
نوع من البكتيريا مثل MRSA
👩🏼🔬ثالثا الاستغناء عن PABA:هذا يقوم بتصنيع حمض الفوليك للبكتيريا والاحماض النووية يمكن تثبيطه عن طريق مجموعة السّلفوناميد لكن البكتيريا المقاومه ل السّلفوناميد تستغني عنه وتاخذ الفوليك من محيطها..
👩🏼🔬ثالثا الاستغناء عن PABA:هذا يقوم بتصنيع حمض الفوليك للبكتيريا والاحماض النووية يمكن تثبيطه عن طريق مجموعة السّلفوناميد لكن البكتيريا المقاومه ل السّلفوناميد تستغني عنه وتاخذ الفوليك من محيطها..
👩🏼🔬واخيرا التّقليل من تراكم المضادّ الحيويّ: عن طريق التّقليل م ن نفاذيّة المضادّ الحيويّ إلى داخل الخليّة و/أو تسريع التّدفّق النّشط (الضّخّ إلى المحيط) للأدوية عبر الغشاء الخلويّ البكتيريّ.
جاري تحميل الاقتراحات...